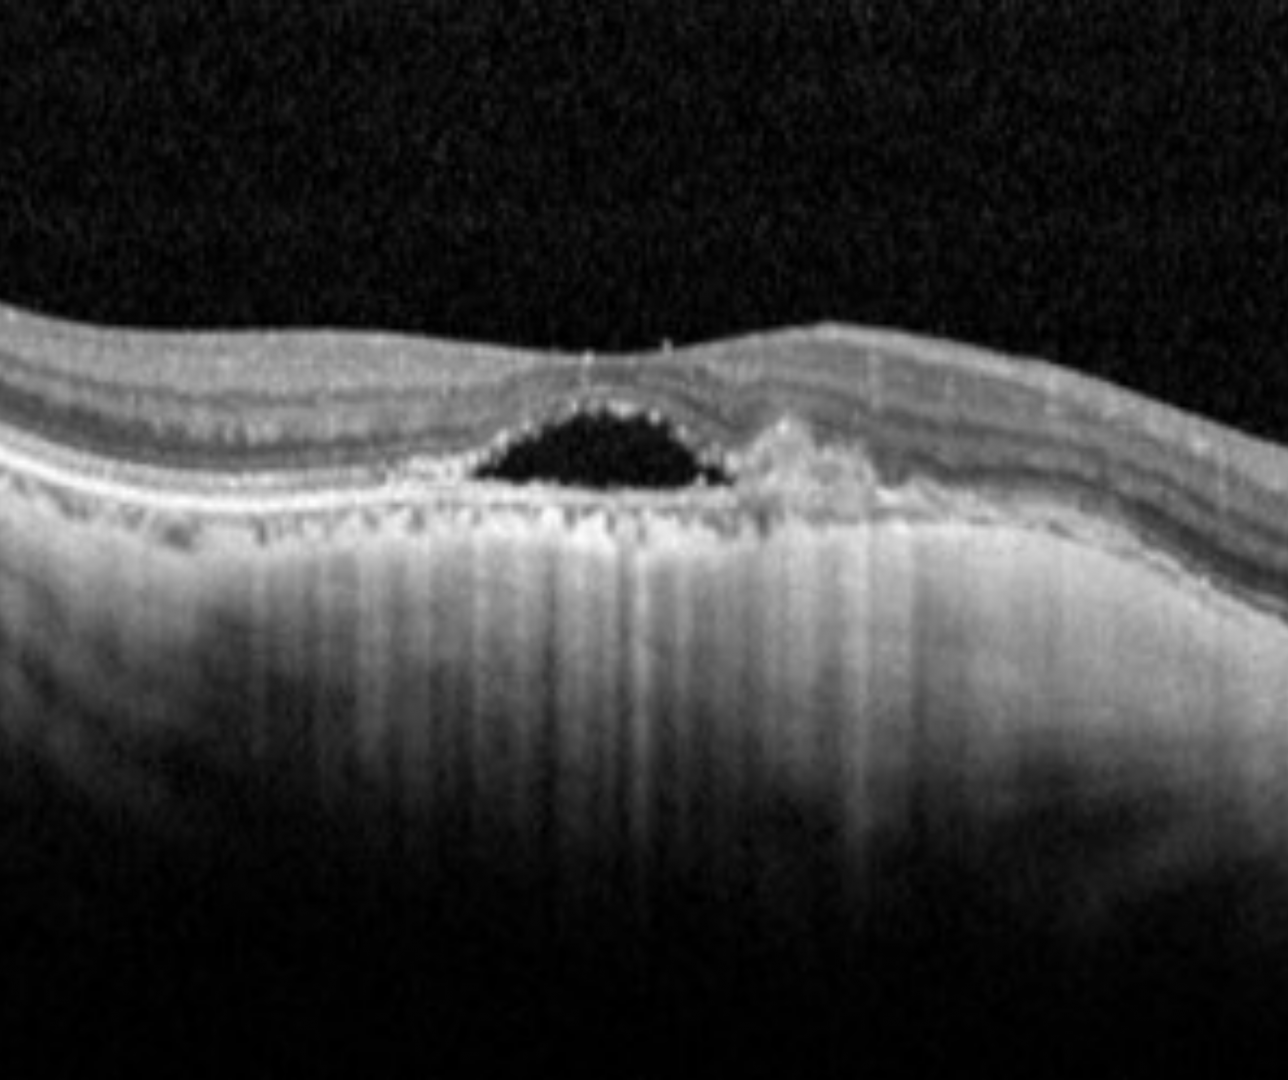

Overview
Myopic CNV is a major sight-threatening complication of myopic maculopathy. Here we will cover the active stage of myopic CNV. There is a link at the bottom of the page to a discussion of regressed myopic CNV (Foster-Fuchs spots). Following regression of the CNV, chorioretinal atrophy can develop resulting in a poor visual prognosis.
Lesions predisposing to myopic CNV include lacquer cracks and breaks in Bruch's membrane at the macula.
Myopic CNV commonly presents as a choroidal neovascular membrane above the RPE in the sub-retinal space (Type 2 CNV). This is distinct from the choroidal neovascularisation associated with age-related macular degeneration (type 1 CNV) which is found in the sub-RPE space.
In the active phase, there may be leakage and patients can develop sudden visual loss and this is seen on OCT as sub and/or intra-retinal fluid.
Funduscopy: can appear as a small, greyish membrane typically near the fovea.
On OCT appears as a subretinal hyperreflective dome-shaped elevation with possible subretinal or intraretinal fluid. In the scarring phase, the lesion can become flatter and RPE hyperplasia may be seen. In the final atrophic phase, chorioretinal atrophy will be seen.
Fundus autofluorescence shows patchy hypo/hyper autofluorescence signal and may have a hyperfluorescent border.
OCT-A reveals a hyper reflective network that may exhibit a tangled or interlaced pattern.
Case Examples
-
Case 1
A 64 year old Caucasian female with refraction -3.50 / -1.25 x 170 and visual acuity of 6/15 (20/50).
-
Case 2
A 50 year old Caucasian female with refraction -17.00 DS and best corrected visual acuity of 6/9- (20/30-).
-
Case 3
A 55 year old Asian female presented for examination. Pinhole visual acuity was 6/15-2 (OD)
Refraction was -15.25/-1.00 x 50 (OD)
Amsler grid was clear in both eyes.
Differential Diagnosis
References
Ng, D., Cheung, C., Luk, F. et al. (2016) Advances of optical coherence tomography in myopia and pathologic myopia. Eye 30, 901–916
Yasushi, I. (2017) Overview of the complications of high myopia, Retina: Volume 37 - Issue 12 - p 2347-2351
Ohno-Matsui, K., Ikuno, Y., Lai, TTI., Cheung, CMG (2018) Diagnosis and treatment guideline for myopic choroidal neovascularization due to pathologic myopia. Progress in Retinal and Eye Research, Volume 63, Pages 92-106,
Milani, P., Massacesi, A., Moschini, S., Setaccioli, M., Bulone, E., Tremolada, G., Ciaccia, S., Mantovani, E., Morale, D., & Bergamini, F. (2016). Multimodal imaging and diagnosis of myopic choroidal neovascularization in Caucasians. Clinical ophthalmology (Auckland, N.Z.), 10, 1749–1757.